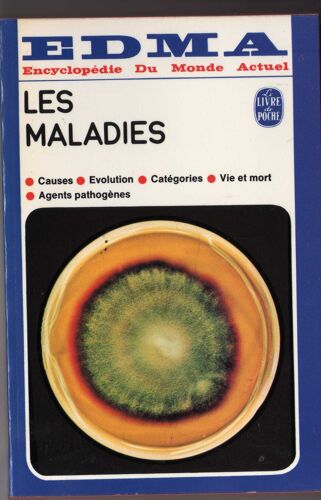
Les Maladies

- Accueil
- Livres
- Autres catégories
- Charles-henri favrod
Charles-Henri Favrod
98 résultats
Meilleures ventes
A propos de «Meilleures ventes»
- Format: Broché
Neuf à 39,90 €
Vendez le vôtre
Neuf à 8,40 €
Occasion dès 0,90 €
Vendez le vôtre
- Collection: PHOTO POCHE
- Format: Poche
1 avis
Neuf à 13 €
Occasion dès 10,61 €
Vendez le vôtre
- Format: Broché
Neuf à 9,90 €
Occasion dès 10,41 €
Vendez le vôtre
- Format: Broché
Neuf à 23 €
Occasion dès 9,68 €
Vendez le vôtre
- Format: Broché
Neuf à 14 €
Occasion dès 4,98 €
Vendez le vôtre
- Format: Poche
1 avis
Neuf à 3,19 €
Occasion dès 0,90 €
Vendez le vôtre
- Collection: Archigraphy Poche
- Format: Broché
Neuf à 10,15 €
Occasion dès 4 €
Vendez le vôtre
- Format: Relié
Occasion dès 20 €
Vendez le vôtre
Occasion dès 3 €
Vendez le vôtre
- Collection: Le Temps Des Passeurs
- Format: Broché
Occasion dès 4,70 €
Vendez le vôtre
- Format: Broché
Occasion dès 10 €
Vendez le vôtre
- Format: Beau livre
Occasion dès 49,90 €
Vendez le vôtre
- Format: Broché
Occasion dès 8 €
Vendez le vôtre
- Format: Broché
Occasion dès 12 €
Vendez le vôtre
- Format: Broché
Occasion dès 30 €
Vendez le vôtre
Occasion dès 12 €
Vendez le vôtre
- Format: Broché
Occasion dès 2 €
Vendez le vôtre
- Format: Broché
Occasion dès 35,80 €
Vendez le vôtre
- Format: Broché
Occasion dès 15 €
Vendez le vôtre
Occasion dès 20,90 €
Vendez le vôtre
- Collection: Livre de poche
- Format: Poche
1 avis
Occasion dès 5,25 €
Vendez le vôtre
- Format: Poche
Occasion dès 6,18 €
Vendez le vôtre
- Format: Cartonné
Occasion dès 15 €
Vendez le vôtre
- Format: Poche
Occasion dès 1,40 €
Vendez le vôtre
- Format: Broché
Occasion dès 7,26 €
Vendez le vôtre
- Format: Poche
Occasion dès 1,40 €
Vendez le vôtre
- Format: Broché
Occasion dès 5 €
Vendez le vôtre
- Format: Broché
Occasion dès 55,50 €
Vendez le vôtre
- Format: Poche
Occasion dès 1,50 €
Vendez le vôtre
- Format: Non Precisé
Occasion dès 1,90 €
Vendez le vôtre
- Format: Broché
Occasion dès 55,50 €
Vendez le vôtre
- Format: Poche
Occasion dès 0,90 €
Vendez le vôtre
- Format: Broché
Occasion dès 20,90 €
Vendez le vôtre
- Format: Broché
Occasion dès 6 €
Vendez le vôtre
- 1
- 2
- 3


















![Voyages Et Aventures De Charles Frédéric Jérome Baron De Munchausen [Transcription De Charles Henri Favrod Selon Le Texte Allemand De Hilaire Le Gai]](https://fr.shopping.rakuten.com/pictures/0199b2c5-fc29-7337-a4a9-8716253c6daf_L_NOPAD.jpg)